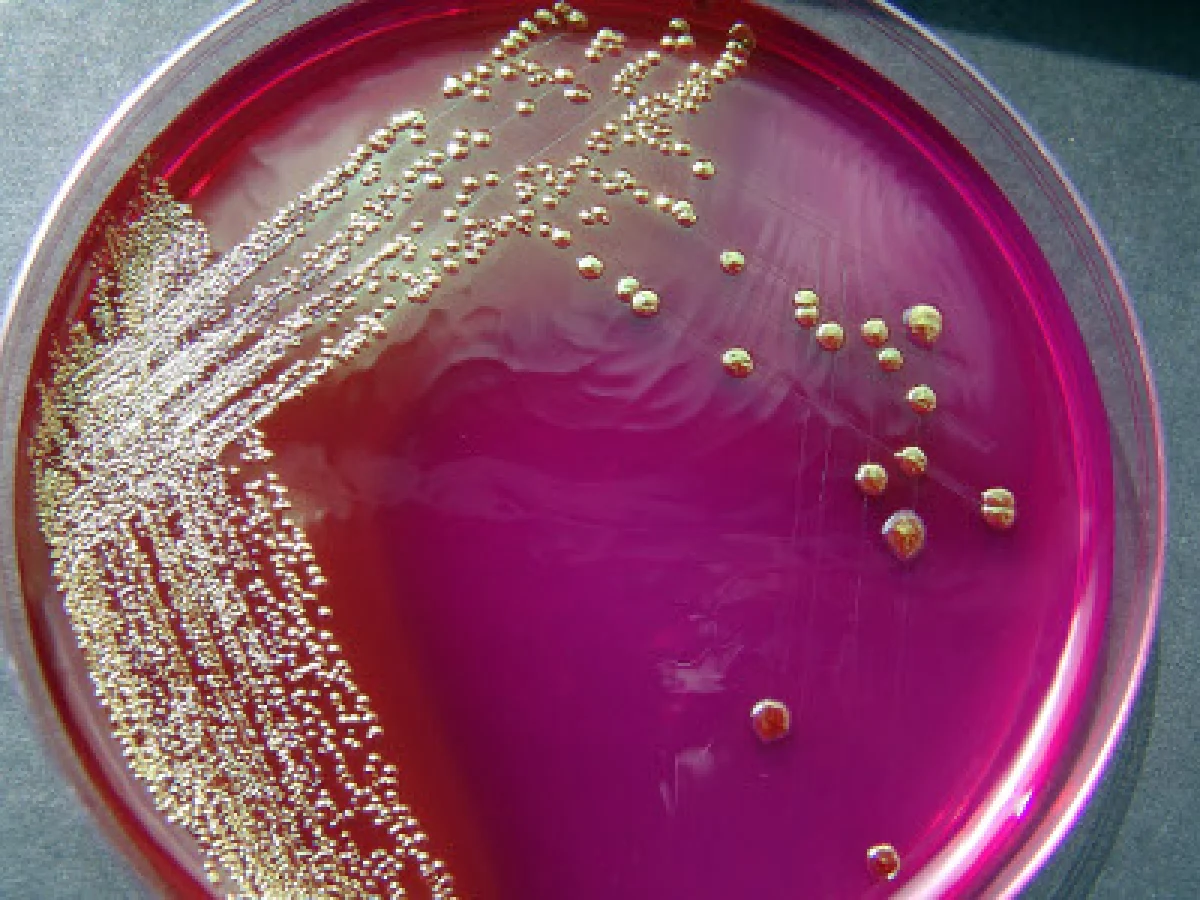

В Тульской области выявлен лейкоз
За период с 23.11.15 г. по 27.11.15 г. отделом серологии ФГБУ «Тульская МВЛ» было проведено 634 исследования крови сельскохозяйственных животных
на бруцеллез, листериоз, хламидиоз, инфекционный эпидидимит, лептоспироз, лейкоз
(серологические и гематологические исследования); лошадей на сап, случную болезнь/
Один из вариантов оздоровления крупного рогатого скота от лейкоза в хозяйстве до 10% инфицированных:
-Одновременная сдача на мясокомбинат инфицированных животных всех возрастных групп или перевод их в группу откорма;
-Серологический контроль остальных животных в РИД с интервалом 3 месяца;
-Объявление пункта благополучным по лейкозу при получении двух подряд отрицательных результатов в РИД;
-Контроль благополучия по ВЛКРС-инфекции методом РИД 1 раз в год.